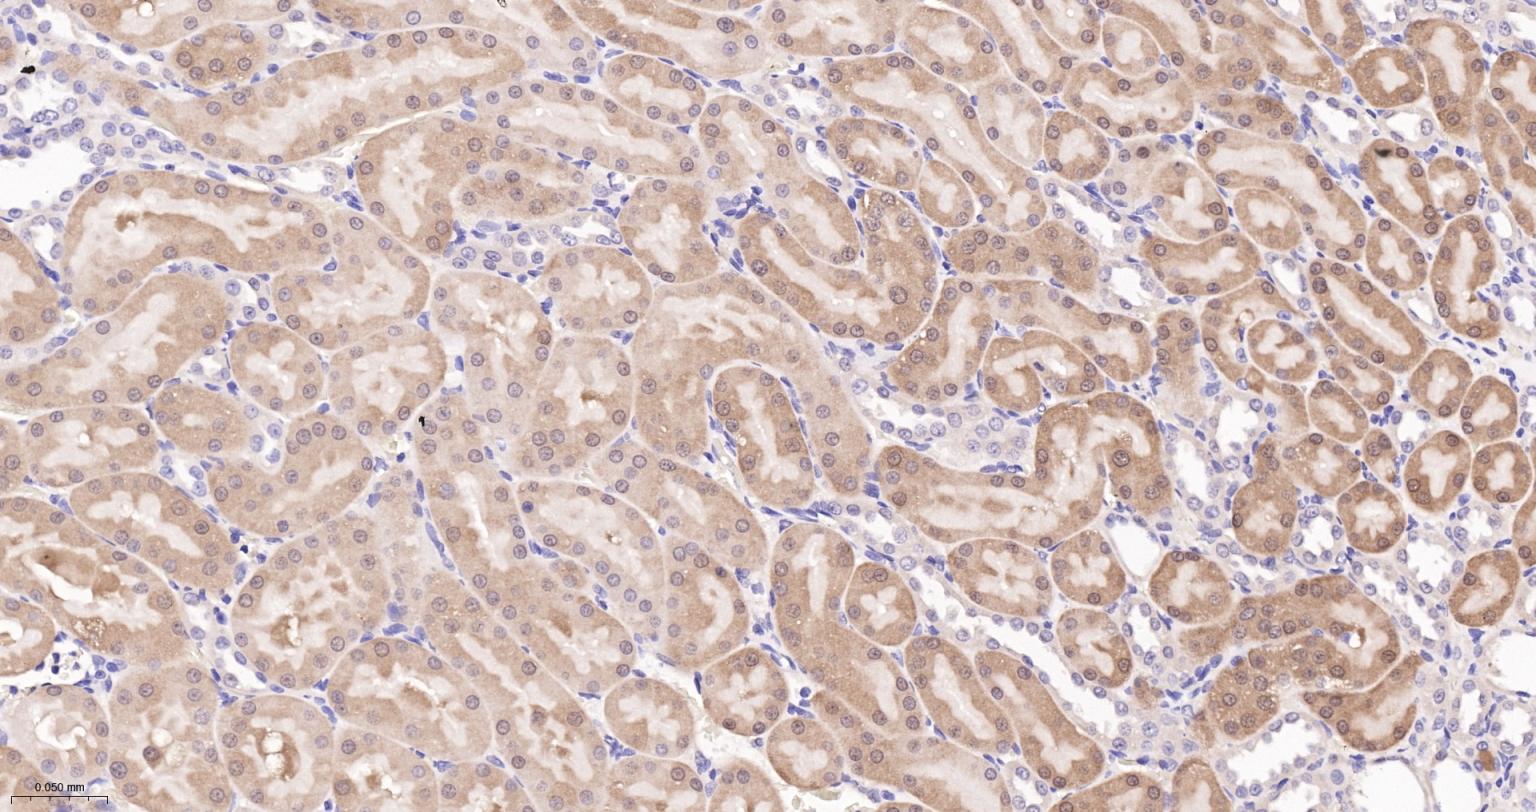
谷胱甘肽过氧化酶4重组兔单抗

谷胱甘肽过氧化物酶(GSH-Px)是机体内广泛存在的一种重要的过氧化物分解酶。硒是GSH-Px酶系的组成成分,它能催化GSH变为GSSG,使有毒的过氧化物还原成无毒的羟基化合物,同时促进H2O2的分解,从而保护细胞膜的结构及功能不受过氧化物的干扰及损害。GSH-Px的活性中心是硒半胱氨酸,其活力大小可以反映机体硒水平。GSH-Px酶系主要包括4种不同的GSH-Px,分别为胞浆GSH-Px、血浆GSH-Px、磷脂氢过氧化物GSH-Px及胃肠道专属性GSH-Px。胞浆GSH-Px由4个相同的分子量大小为22kDa的亚基构成四聚体,每个亚基含有1个分子硒半胱氨酸,广泛存在于机体内各个组织,以肝脏红细胞为最多。它的生理功能主要是催化GSH参与过氧化反应,清除在细胞呼吸代谢过程中产生的过氧化物和羟自由基,从而减轻细胞膜多不饱和脂肪酸的过氧化作用。

| 应用 | 已检合格种属 | 预测种属 | 推荐稀释比例 |
|---|---|---|---|
| WB | Human, Mouse, Rat | 1:1000-2000 | |
| IHC-P | Human, Mouse, Rat | 1:100-500 | |
| IHC-F | Human, Mouse, Rat | 1:100-500 | |
| IF | Human, Mouse, Rat | 1:100-500 | |
| ICC/IF | Human, Mouse, Rat | 1:100-200 |
交叉反应: Human, Mouse, Rat
暂无相关产品
暂无标记数据
暂无同靶标产品
暂无相关文献
暂无常见问题